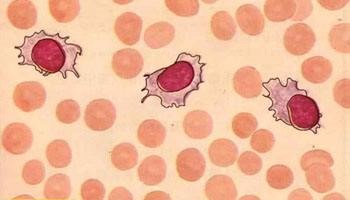

阿斯利康新藥治療罕見白血病獲FDA優先評審資格
編輯:全球華人抗癌新藥網 來源:全球華人抗癌新藥網 發佈時間:2018-04-17
近日,美國FDA接受了阿斯利康新藥moxetumomab pasudotox的生物製劑許可申請(BLA),用於治療至少接受過兩次治療的毛細胞白血病(HCL)成人患者的治療,並授予其優先評審資格。
毛細胞白血病,是一種進展緩慢的淋巴增殖性慢性白血病,以貧血、出血、脾臟腫大及外周血及骨髓出現大量邊緣不整齊呈偽足狀或纖毛樣突出的白細胞為特徵。此種病的本質尚未十分明確,多見於40歲以上男性。HCL可導致嚴重甚至危及生命的疾病,比如感染、出血和貧血,儘管許多患者最初對治療有反應,但高達40%的患者會復發。由於沒有確定的標準治療方案和極少的治療方法,復發性或難治性HCL患者仍存在重大的未滿足醫療需求。
此次的優先評審是基於一項Ⅲ期臨床研究(Study 1053)的資料。該研究是一項單臂、多中心III期研究,在80例既往接受了至少2種方案的復發性或難治性HCL成人患者中開展,評估了moxetumomab pasudotox單藥治療的療效和安全性。目前,該研究正在全球14個國家34個治療中心開展。來自該研究的資料顯示,moxetumomab pasudotox單藥治療達到了持久完全緩解的主要終點。研究的詳細資料將在即將召開的醫學會議上公佈。
moxetumomab pasudotox是一種實驗性抗CD-22重組免疫毒素,是一類抗癌製劑,利用了抗體的選擇性來靶向藥物遞送以及毒素強效殺傷癌細胞的能力。moxetumomab pasudotox由一種抗CD22抗體的結合域與毒素融合而成。CD22是一種主要在成熟B淋巴細胞中表達的I型跨膜蛋白,在B細胞信號傳導中起重要作用。與正常B細胞相比,HCL細胞上存在更高密度的CD22,這使其成為治療HCL的一個非常有吸引力的治療靶標。
moxetumomab pasudotox曾被FDA授予孤兒藥資格,治療HCL。獲得優先評審資格的藥物,FDA將給予加速審查並在6個月完成審查,而非常規的10個月。我們期待這款新藥能順利獲得審批,儘快為這類罕見癌症患者帶來治療的曙光。
